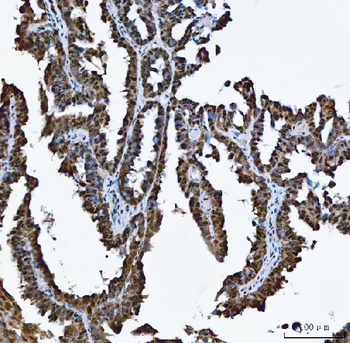

You have no items in your shopping cart.
Search results for: 'antibodies'
- Anti-SEMA4F Antibody [orb1402101]
ELISA, FC, ICC, IF, IHC, WB
Human, Mouse, Rat
Rabbit
Polyclonal
Unconjugated
10 μg, 100 μg - Anti-TRMT10C Antibody [orb1291638]
ELISA, FC, ICC, IF, IHC, WB
Human
Rabbit
Polyclonal
Unconjugated
10 μg, 100 μg - Anti-AREB6/ZEB1 Antibody (monoclonal, 8B12D7) [orb1184754]Featured

ICC, IF, IHC, WB
Human, Mouse, Rat
Mouse
Monoclonal
Unconjugated
10 μg, 100 μg - Anti-Proteasome 20S beta 7/PSMB7 Antibody [orb1145803]
ELISA, FC, ICC, IF, IHC, WB
Human, Mouse, Rat
Rabbit
Polyclonal
Unconjugated
100 μg, 10 μg - Anti-HnRNP A1/HNRNPA1 Antibody [orb389413]
FC, ICC, IF, IHC, WB
Human, Mouse, Rat
Rabbit
Polyclonal
Unconjugated
100 μg, 10 μg - Anti-Annexin V/ANXA5 Antibody [orb182376]
FC, ICC, IF, IHC, WB
Human, Mouse, Rat
Rabbit
Polyclonal
Unconjugated
10 μg, 100 μg - Anti-IDH2 Antibody [orb312128]
ICC, IF, IHC, WB
Human, Mouse, Rat
Rabbit
Polyclonal
Unconjugated
100 μg, 10 μg - Anti-Cyclophilin A/PPIA Antibody [orb19174]
FC, ICC, IF, IHC, IHC-Fr, WB
Human, Mouse, Rat
Rabbit
Polyclonal
Unconjugated
10 μg, 100 μg - HSPA8 Rabbit Polyclonal Antibody [orb330554]
IHC, WB
Human, Mouse, Rat
Bovine, Goat, Porcine, Sheep, Zebrafish
Rabbit
Polyclonal
Unconjugated
100 μl - SOX9 antibody [orb4387]Featured

ICC, IF, IHC-P, WB
Human, Mouse, Porcine, Rat
Rabbit
Polyclonal
Unconjugated
100 μg